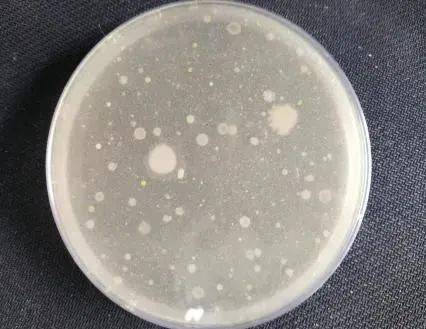

不想得

空调病
+++
这个动作很重要

先给空调洗个澡
气温攀升
又到空调使用季
*记得先给空调洗个澡*

伴随着逐渐攀升的气温
闲置很久的空调
就迫不及待地要打开了~
注意:
空调长时间未使用或室内空气质量不良时,会积累大量灰尘,为微生物生长提供条件,极大可能影响人类健康。
空调内部的微生物随着空调的运行散播到室内空气中,可能引起皮肤过敏、哮喘、肺炎等疾病,几乎每年夏天都有因为空调病进ICU的新闻。

微生物是怎样对
健康造成危害的呢
实际上,空调中的微生物主要来自于室内空气。如果我们没有保持室内干净整洁,经常通风换气以及定期清洗空调的习惯,那么我们就很可能会因与致病菌亲密接触而患病。

空调的卫生状况对
健康产生很大影响吗
答案是肯定的
★ 由于致病菌污染空调,而导致人群健康损害的事件已经遍及世界各国,并引起了各国政府的高度重视。
★对于集中空调通风系统我国已经有国家卫生标准和严格的卫生监督制度进行监管,以保障广大群众的健康。
★而家用空调的卫生状况则需要人们自身提高认识,定期维护保养,从而达到预防疾病的目的。

未及时清洗的
空调到底有多脏呢?
我们拿出了一个室内卫生条件还不错的家中使用了1年的空调滤网,上面布满了灰尘和棉絮状的物质,让人感觉特别脏,很不舒服。

但是,这个世界上偏偏就有这么一群生物特别喜欢这样的环境,它们就是肉眼看不到的微生物。一旦这些微生物占领了空调滤网,便会抓紧时机在滤网上迅速繁殖,这也为它们更好的进军下一个阵地而做好准备。

当我们打开这样一个没有清洗过的空调时,大量的微生物被吹到室内空气中,一个健康的人吸入大量的致病微生物后,便可能被击倒了。
因此建议空调在长期不用重新开启前一定要对其进行简单清洁。

特别是对家中有体弱多病者或有过呼吸道传染病病人的空调,更应加强清洗工作。
我们该如何清洗空调呢
01
断电!断电!断电!
重要事情说三遍。

02
然后打开空调面板,取出空调过滤网。

03
清洗过滤网,可用空调专用清洗剂清洗处理污垢然后清水洗净,需自然晾干。

04
用半干的抹布擦拭空调内部面板。

05
先将面板进行关闭复位后,再擦拭空调面板即可。


经试验证实用清水直接冲洗空调滤网,滤网上的细菌总数能大大减少,而浸泡了消毒液的空调滤网,可以达到检测不到细菌的程度,这说明浸泡消毒液的清洗效果更好。

*
让我们来看下实验结果!
清洗前

清水清洗1分钟
浸泡30分钟消毒液再清水清洗

好了,在了解了家用空调清洗的必要性及清洗步骤后,在炎热的天气来临前,小伙伴们赶紧行动起来,帮家里的空调洗洗澡吧!
小贴士:

适当开窗通风
★开空调时适当开窗通风,提高房间换气次数,避免长时间封闭。

车辆保养
★车载空调的清洁也不能少。车辆保养时,别忘了检查空调系统、冷凝器,及时更换空调滤芯。

总之
无论是中央空调系统、分体式家用空调
还是车载空调,
都是需要定期清洗和维护的!
供稿:市疾控中心环境卫生所 张雅婕
编辑:Suki